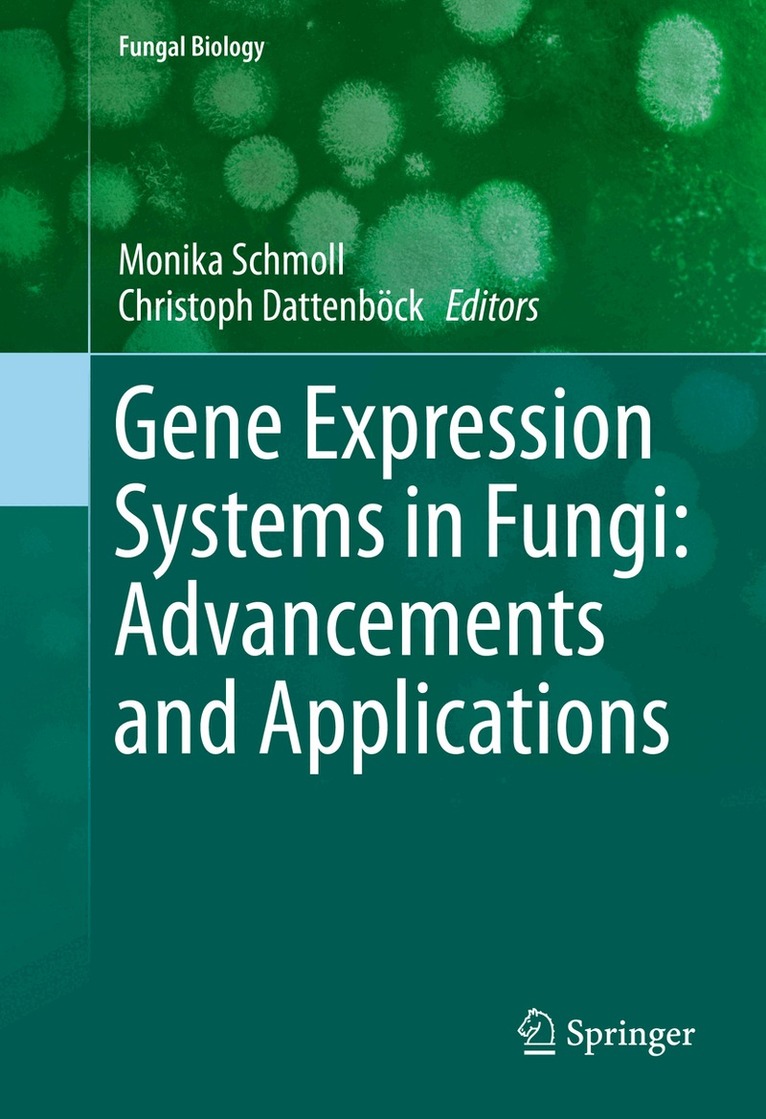
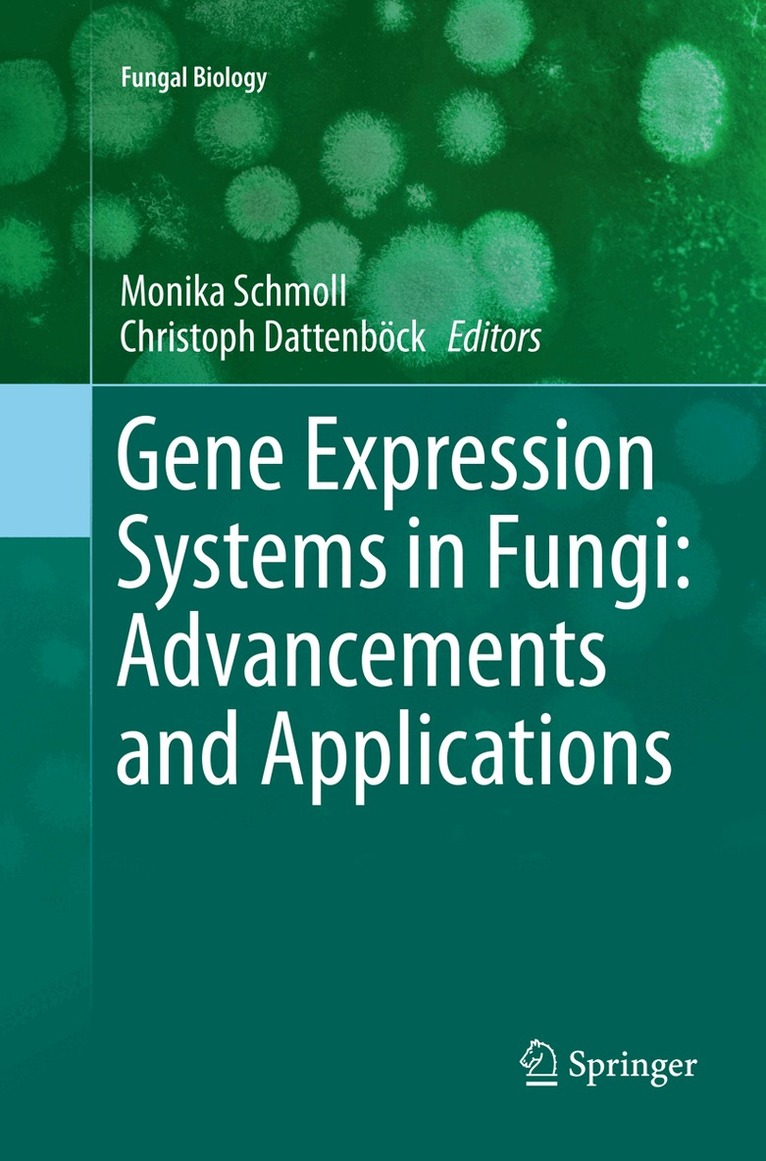

Monika Schmoll – författare
Visar alla böcker från författaren Monika Schmoll. Handla med fri frakt och snabb leverans.
12 produkter
12 produkter
Häftad, Engelska, 2019
948 kr
Skickas inom 10-15 vardagar
The microbial engineering technologies have been identified as an essential and important subject area of engineering and applied biological sciences. A microbial engineer works on the biological, chemical and engineering aspects of biotechnology, manipulating microbes and developing new uses for microbes. In agriculture, bioprocess engineering, in biotechnology, genetic engineering, microbial vaccines, and the development of bionanotechnology, microbial engineering could be recognized as high potential technologies in the current scenario for economic development. Scientists and engineers are motivated for sustainable green technology as a part of an upcoming industrial revolution turning more and more to processes involving microorganisms.Applications of Microbial Engineering provides a better understanding of industrially important genetically manipulated and engineered prokaryotic and eukaryotic cell systems. The content of this book are based on most recent developments in microbial engineering. The contributions by specialists on the respective topics provide a profound scientific basis for further research. It is expected that this book will be a valuable resource for researchers as well as students dealing with microbiology and biotechnology.
Inbunden, Engelska, 2014
1 798 kr
Skickas inom 10-15 vardagar
Biotechnology and Biology of Trichoderma serves as a comprehensive reference on the chemistry and biochemistry of one of the most important microbial agents, Trichoderma, and its use in an increased number of industrial bioprocesses for the synthesis of many biochemicals such as pharmaceuticals and biofuels. This book provides individuals working in the field of Trichoderma, especially biochemical engineers, biochemists and biotechnologists, important information on how these valuable fungi can contribute to the production of a wide range of products of commercial and ecological interest. Provides a detailed and comprehensive coverage of the chemistry, biochemistry and biotechnology of Trichoderma, fungi present in soil and plants Includes most important current and potential applications of Trichoderma in bioengineering, bioprocess technology including bioenergy & biofuels, biopharmaceuticals, secondary metabolites and protein engineering Includes the most recent research advancements made on Trichoderma applications in plant biotechnology and ecology and environment
E-bok
Engelska, 20142 061 kr
Läs direkt efter köp
Biotechnology and Biology of Trichoderma serves as a comprehensive reference on the chemistry and biochemistry of one of the most important microbial agents, Trichoderma, and its use in an increased number of industrial bioprocesses for the synthesis of many biochemicals such as pharmaceuticals and biofuels. This book provides individuals working in the field of Trichoderma, especially biochemical engineers, biochemists and biotechnologists, important information on how these valuable fungi can contribute to the production of a wide range of products of commercial and ecological interest.- Provides a detailed and comprehensive coverage of the chemistry, biochemistry and biotechnology of Trichoderma, fungi present in soil and plants- Includes most important current and potential applications of Trichoderma in bioengineering, bioprocess technology including bioenergy & biofuels, biopharmaceuticals, secondary metabolites and protein engineering- Includes the most recent research advancements made on Trichoderma applications in plant biotechnology and ecology and environment
Inbunden, Engelska, 2013
3 258 kr
Skickas inom 10-15 vardagar
The microbial engineering technologies have been identified as an essential and important subject area of engineering and applied biological sciences. A microbial engineer works on the biological, chemical and engineering aspects of biotechnology, manipulating microbes and developing new uses for microbes. In agriculture, bioprocess engineering, in biotechnology, genetic engineering, microbial vaccines, and the development of bionanotechnology, microbial engineering could be recognized as high potential technologies in the current scenario for economic development. Scientists and engineers are motivated for sustainable green technology as a part of an upcoming industrial revolution turning more and more to processes involving microorganisms.Applications of Microbial Engineering provides a better understanding of industrially important genetically manipulated and engineered prokaryotic and eukaryotic cell systems. The content of this book are based on most recent developments in microbial engineering. The contributions by specialists on the respective topics provide a profound scientific basis for further research. It is expected that this book will be a valuable resource for researchers as well as students dealing with microbiology and biotechnology.
E-bok
PDF, Engelska, 20131 103 kr
Läs direkt efter köp
Applications of Microbial Engineering provides a better understanding of industrially important genetically manipulated and engineered prokaryotic and eukaryotic cell systems. The content of this book are based on most recent developments in microbial engineering. The contributions by specialists on the respective topics provide a profound scientific basis for further research. It is expected that this book will be a valuable resource for researchers as well as students dealing with microbiology and biotechnology.
Inbunden, Engelska, 2013
1 797 kr
Skickas inom 5-8 vardagar
Trichoderma spp. are biotechnologically significant fungi, being widely used both in agriculture and industry. These microbes are also a potential drug source of clinical importance. In recent years, driven by advances in genetics and genomics, research on these fungi have opened new avenues for its varied applications. Divided into three sections, covering taxonomy and physiology, interactions with plants and applications and significance, this book also discusses topics that have seen rapid developments in the recent years. Various aspects of Trichoderma like molecular taxonomy, sexual and asexual developments, secondary metabolism, beneficial interactions with plants, applications as cell factories and harmful interactions with humans are discussed. This book, thus, hopes to be an essential ready reference for researchers, students and people form industry as well.
Del 20 - Techniques in Plantation Science
Trichoderma: Ganoderma Disease Control in Oil Palm
A Manual
Häftad, Engelska, 2019
332 kr
Skickas inom 5-8 vardagar
This is a hands-on practical guide to the use of Trichoderma as a biocontrol, as part of sustainable disease control measures for Ganoderma disease in oil palm plantations. The manual provides background information on Ganoderma (basal stem rot), the most devastating disease of oil palm in Southeast Asia, as well as on the benefits of Trichoderma fungi in safe guarding yields. The disease is caused by soil-borne fungi, Ganoderma spp, which are found in West Africa and South America, as well as Southeast Asia. Practical information is given on: the use of Trichoderma to manage Ganoderma for research and commercial use health and safety considerations in the laboratory, nursery and field in vitro multiplication of Trichoderma starting from media preparation and culture Ganoderma pathogenicity testing Trichoderma in vitro antagonism screening of Ganoderma Trichoderma screening to protect seedlings scoring Ganoderma response to Trichoderma in selecting aggressive Trichoderma isolates commercial use and application in oil palm plantations This is an invaluable manual for oil palm growers, estate/plantation managers, pathologists and breeders and research institutes across the world (especially tropical zones). It is also useful for those starting a career in oil palm plant protection, and as a reference guide for managers and for training purposes.
Del 20 - Techniques in Plantation Science
Trichoderma: Ganoderma Disease Control in Oil Palm
A Manual
E-bok
PDF, Engelska, 2019331 kr
Läs direkt efter köp
This is a hands-on practical guide to the use of Trichoderma as a biocontrol, as part of sustainable disease control measures for Ganoderma disease in oil palm plantations. The manual provides background information on Ganoderma (basal stem rot), the most devastating disease of oil palm in Southeast Asia, as well as on the benefits of Trichoderma fungi in safe guarding yields. The disease is caused by soil-borne fungi, Ganoderma spp, which are found in West Africa and South America, as well as Southeast Asia. Practical information is given on: the use of Trichoderma to manage Ganoderma for research and commercial use health and safety considerations in the laboratory, nursery and field in vitro multiplication of Trichoderma starting from media preparation and culture Ganoderma pathogenicity testing Trichoderma in vitro antagonism screening of Ganoderma Trichoderma screening to protect seedlings scoring Ganoderma response to Trichoderma in selecting aggressive Trichoderma isolates commercial use and application in oil palm plantations This is an invaluable manual for oil palm growers, estate/plantation managers, pathologists and breeders and research institutes across the world (especially tropical zones). It is also useful for those starting a career in oil palm plant protection, and as a reference guide for managers and for training purposes.
Del 20 - Techniques in Plantation Science
Trichoderma: Ganoderma Disease Control in Oil Palm
A Manual
E-bok
Engelska, 2019331 kr
Läs direkt efter köp
This is a hands-on practical guide to the use of Trichoderma as a biocontrol, as part of sustainable disease control measures for Ganoderma disease in oil palm plantations. The manual provides background information on Ganoderma (basal stem rot), the most devastating disease of oil palm in Southeast Asia, as well as on the benefits of Trichoderma fungi in safe guarding yields. The disease is caused by soil-borne fungi, Ganoderma spp, which are found in West Africa and South America, as well as Southeast Asia. Practical information is given on: the use of Trichoderma to manage Ganoderma for research and commercial use health and safety considerations in the laboratory, nursery and field in vitro multiplication of Trichoderma starting from media preparation and culture Ganoderma pathogenicity testing Trichoderma in vitro antagonism screening of Ganoderma Trichoderma screening to protect seedlings scoring Ganoderma response to Trichoderma in selecting aggressive Trichoderma isolates commercial use and application in oil palm plantations This is an invaluable manual for oil palm growers, estate/plantation managers, pathologists and breeders and research institutes across the world (especially tropical zones). It is also useful for those starting a career in oil palm plant protection, and as a reference guide for managers and for training purposes.
Inbunden, Engelska, 2016
1 082 kr
Skickas inom 10-15 vardagar
Industrial application and exploitation of the metabolic capacities of fungi requires highly productive and robust gene expression systems, which can be achieved by selection of appropriate species and strain improvement.
E-bok
PDF, Engelska, 20161 379 kr
Läs direkt efter köp
Biotechnology has emerged as one of the key environmentally safe technologies for the future which enables use of biomass to develop novel smart materials and to replace oil derived products. Fungi are the most efficient producers of the enzymes needed for this purpose and in addition they produce a plethora of secondary metabolites, among which novel antibiotics can be found. Industrial application and exploitation of the metabolic capacities of fungi requires highly productive and robust gene expression systems, which can be achieved by selection of appropriate species and strain improvement. In this book we aim to summarize homologous and heterologous gene expression systems of fungi for production of enzymes and secondary metabolites. A broad overview on requirements, challenges and successful applications shall serve as a basis for further development of fungi as biotechnological workhorses in research and industry.
Häftad, Engelska, 2018
1 082 kr
Skickas inom 10-15 vardagar
Industrial application and exploitation of the metabolic capacities of fungi requires highly productive and robust gene expression systems, which can be achieved by selection of appropriate species and strain improvement.